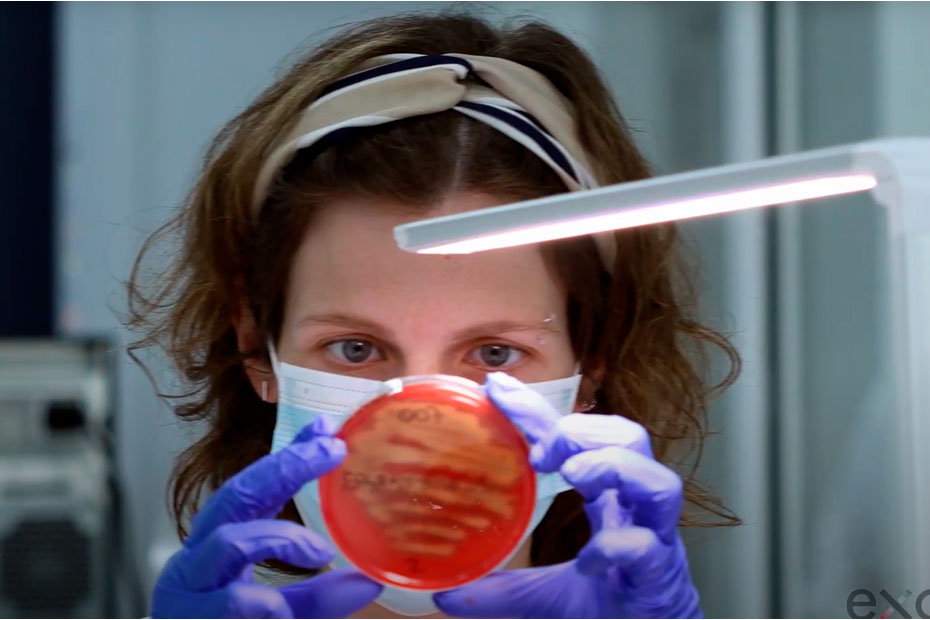
exopol_biotegania

Exopol: tres décadas creando vacunas y soluciones biotecnológicas con la mirada puesta en One Health
Fundada en 1993, Exopol se ha consolidado como una empresa referente en la producción de vacunas autógenas, servicios de diagnóstico avanzado, producción de kits de… Read More »Exopol: tres décadas creando vacunas y soluciones biotecnológicas con la mirada puesta en One Health